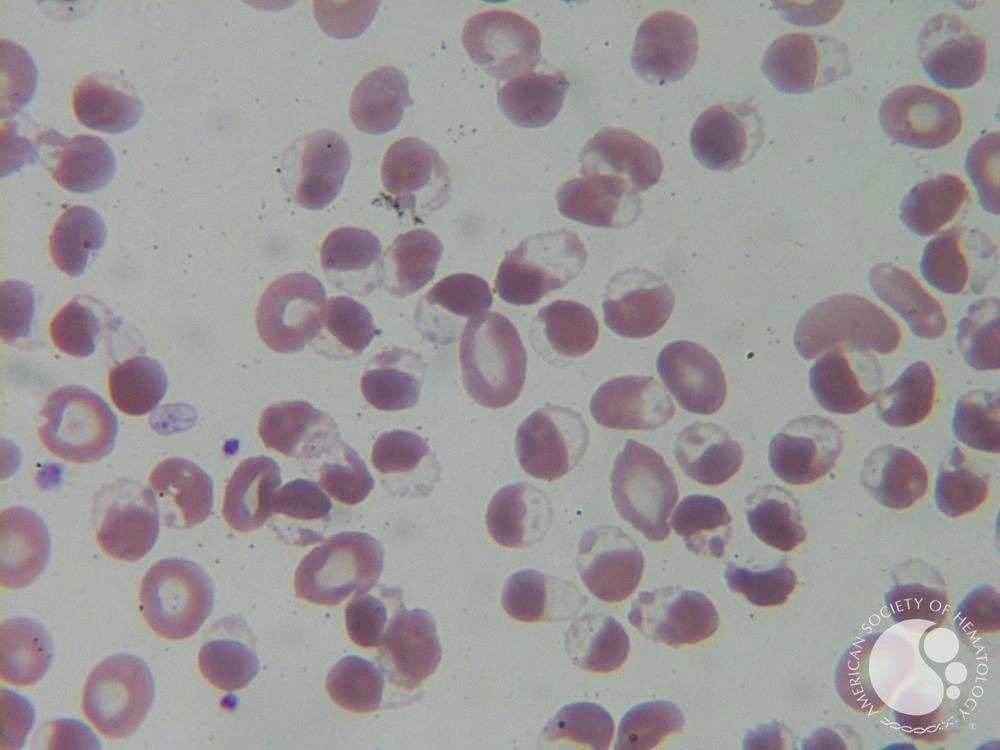

Hematologist • Allogeneic Transplant Unit, Princess Margaret Cancer Centre, Toronto | @UofT • Co-founder @HaemBytes • Member @TheEBMT_Trainee committee
How to get URL link on X (Twitter) App


 Where do you see them?
Where do you see them?

Yeah, those are hemighost cells !
Yeah, those are hemighost cells !
 Now let's see what each spike represents!
Now let's see what each spike represents!


 Let's roll back time 🔙 to the 1960's 😍
Let's roll back time 🔙 to the 1960's 😍
 Before we go any further, it's important to know this
Before we go any further, it's important to know thishttps://twitter.com/nihardesai7/status/1587702610038968320?t=LSp3UWci_by6Mh1JCqWXyw&s=19




 Let's roll back time, we are in the 1930s in 🇺🇲, the great depression is at its peak and American farmers are losing their cattle 😭
Let's roll back time, we are in the 1930s in 🇺🇲, the great depression is at its peak and American farmers are losing their cattle 😭
 Yes, the CT shows a large hematoma
Yes, the CT shows a large hematoma
 You immediately know what's going on, you ask for an urgent chest imaging. Only a chest Xray is available and shows 👇🏻
You immediately know what's going on, you ask for an urgent chest imaging. Only a chest Xray is available and shows 👇🏻

 Let's start with the causes of hypoxic that don't respond to supplemental oxygen !
Let's start with the causes of hypoxic that don't respond to supplemental oxygen !
 Yeah, this is obviously a Deep Vein Thrombosis (DVT) !
Yeah, this is obviously a Deep Vein Thrombosis (DVT) !



 1st Q: What TRIMESTER ??
1st Q: What TRIMESTER ??